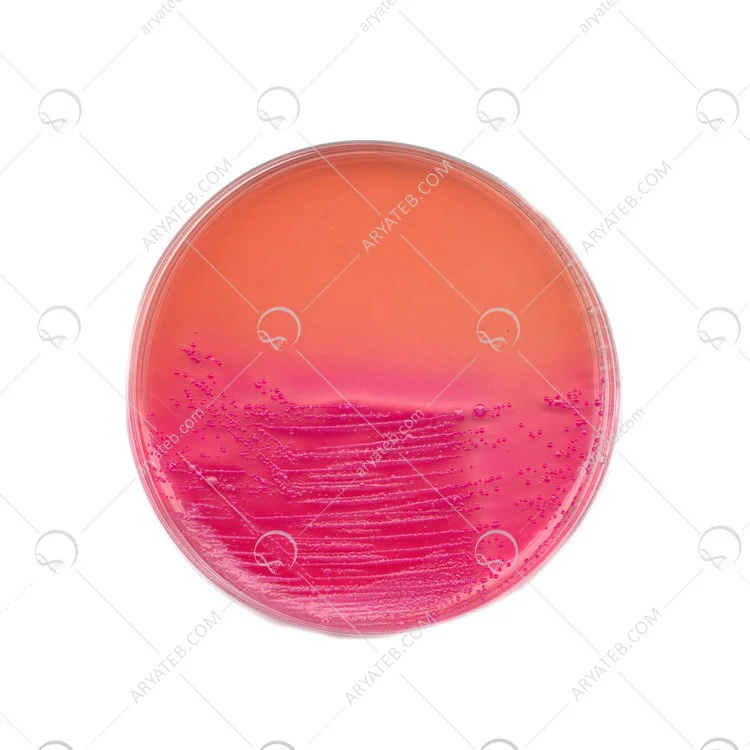

محیط کشت دی سی ای
محیط کشت dca
محیط کشت Dcaa یا محیط کشت dca یکی دیگر از محیط های کشت خلیجی است که توسط مجموعه رژ لب ANO ارائه می شود.محیط کشت دیوکسیلات سیترات آگار فرمول اصلاح شده لیفسون است و برای جداسازی سالمونلا و شیگلا استفاده می شود.این محیط کشت به دلیل افزایش نمک است.سیترات و دگزی کولات نسبتاً برای پاتوژن های روده ای ترجیح داده می شود. محیط کشت DCA با pH 7.3 تا 7.5 برای باکتری های گرم مثبت مثبت است. نمک های سیترات، در فرمولاسیون باکتری های گرم مثبت و اکثر موجودات طبیعی روده به میزان متعادل، این محیط کشت در اصل یک محیط انتخاب و تمایز است که معمولاً برای جداسازی پاتوژن های روده ای استفاده می شود.

محیط کشت Deoxycholate citrate agar
اجزای تشکیل دهنده محیط کشت DCA) Deoxycholate Citrate Agar)

دستورالعمل تهیه و ساخت Deoxycholate Citrate Agar
- 70.52 گرم از محیط کشت را در 1000 میلی لیتر آب مقطر معلق کنید.
- آب را روی آتش بگذارید تا بجوشد تا محیط کاملا حل شود.
- تا دمای 45-50 درجه سانتیگراد خنک شود. ید.
- قبل از استفاده سطح آگار را خشک کنید.
- محیط را به شدت با مدفوع یا سواب رکتوم تلقیح کنید و بخشی از تلقیح اولیه را تا جدا شدن کامل کلنی ها ادامه دهید.
- در دمای 35 درجه سانتیگراد به مدت 18-24 ساعت انکوبه کنید.
- اگر ارگانیسم ها به کندی رشد می کنند یا تخمیرهای بدون لاکتوز مشاهده نشد، برای 24 ساعت دیگر انکوبه کنید.
نتیجه به دست آمده

برای دیدن انواع بیشتر محیط کشت کلیک کنید
آدرس ایمیل شما منتشر نخواهد شد. فیلدهای الزامی علامت گذاری شده اند *